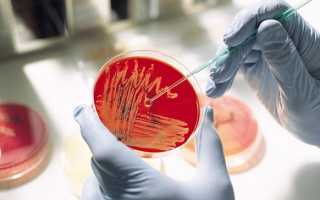

Служба детской и взрослой неотложной помощи, вызова врача на дом, медицинской транспортировки и предрейсовых осмотров
Россия, Красноярск, проспект Металлургов
Телефон:
+7 (391) 203-03-
+7 (391) 203-03-
Круглосуточно
Свежие публикации
Показать ещё